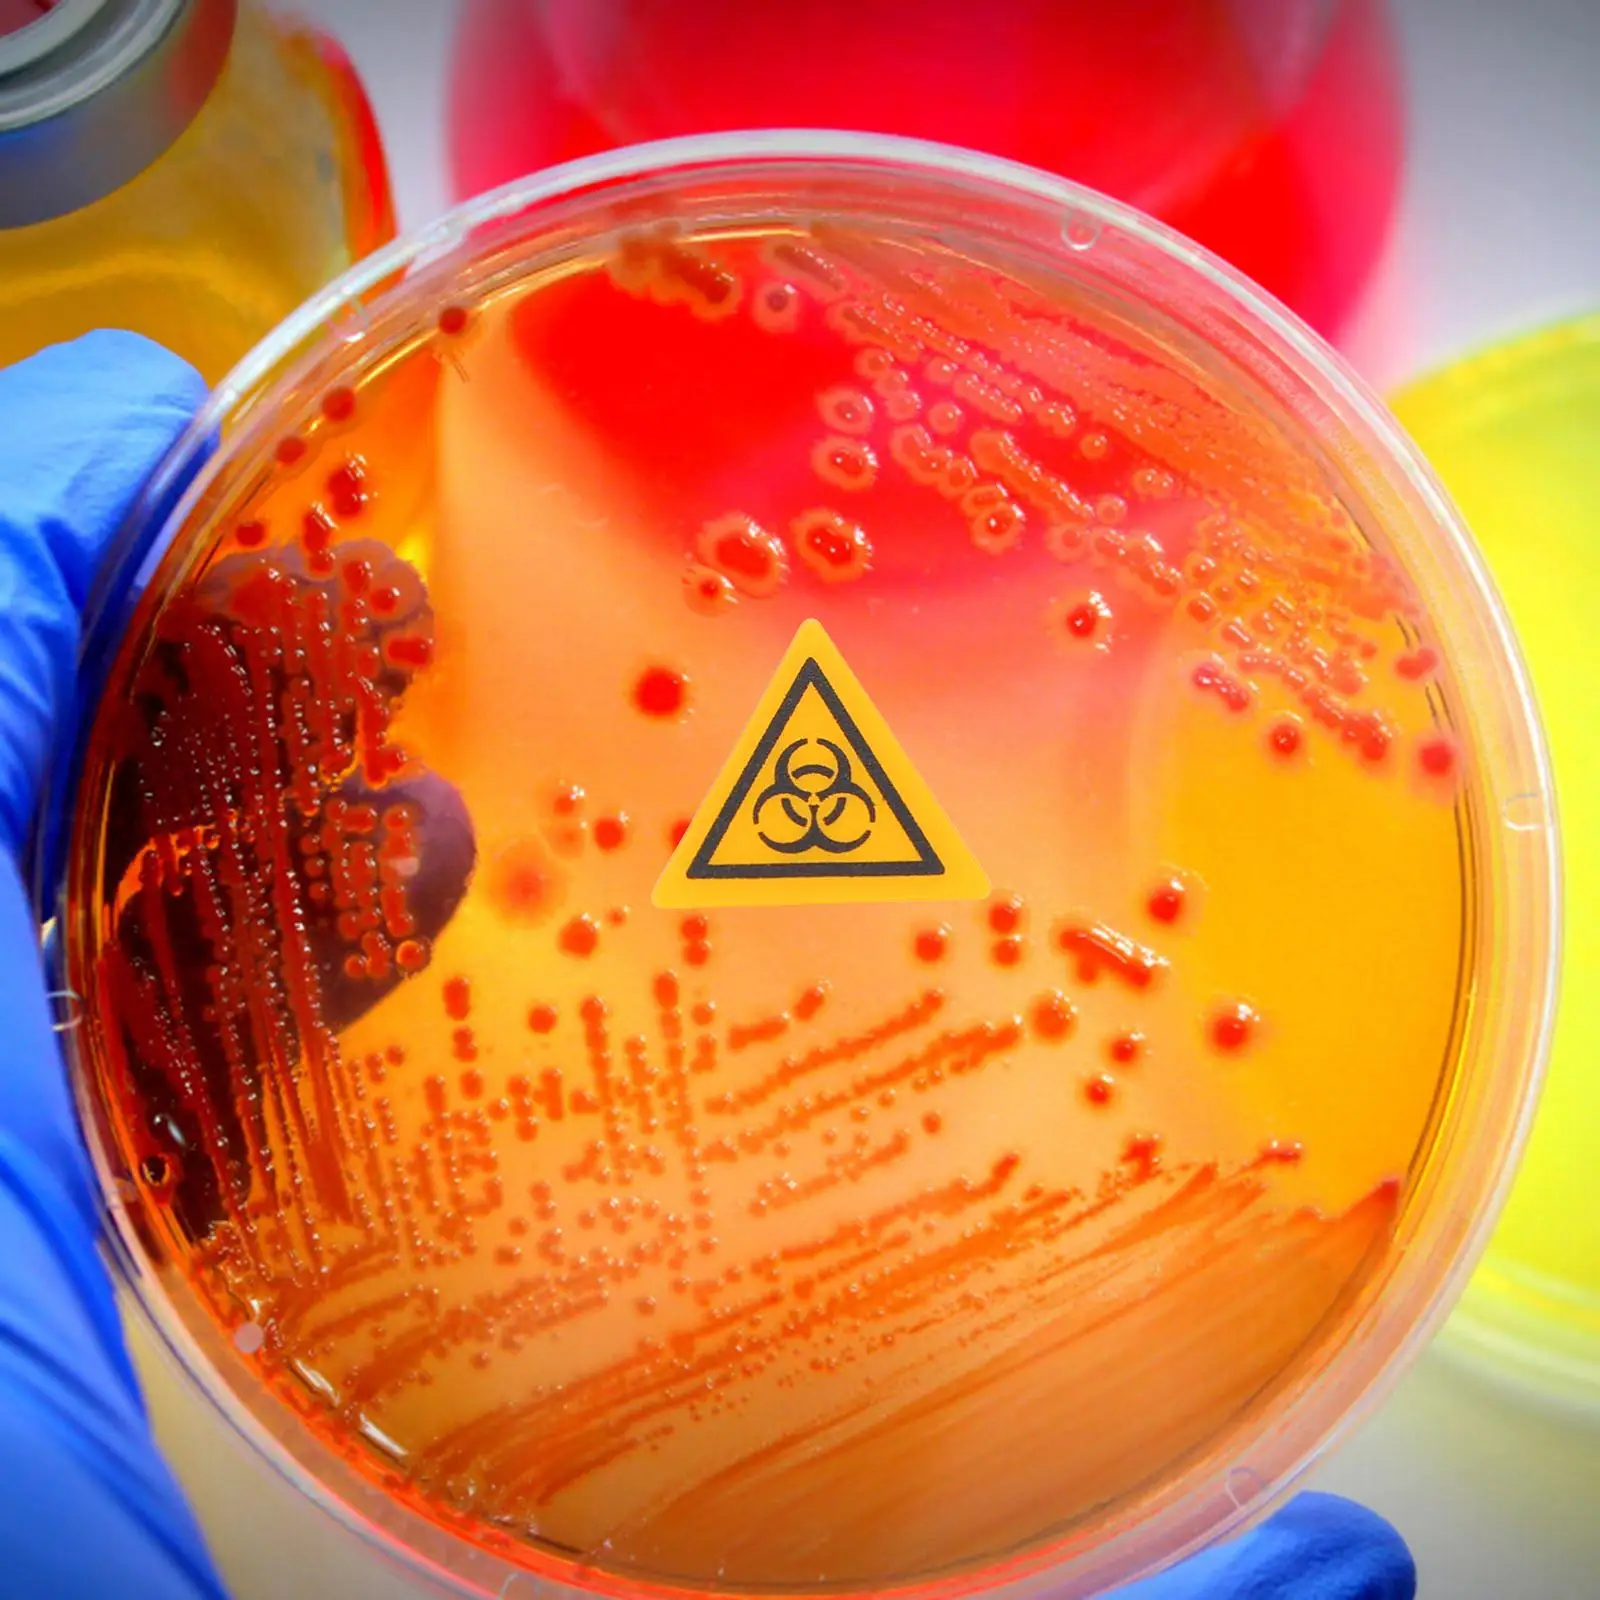
thumb

10pcs Sign Caution Sticker Warning Labels Decals 15MM Self Adhesive Infection Signs Lab Safety Traffic Safety
Price history chart & currency exchange rate
Customers also viewed

$28.81
100% NEWHigh quality products M95256-WMN6TP 95256WP SOP8 MODULE new in stockHigh quality products
aliexpress.com
$9.16
Professional Art Solid Color Face Paint Matte Water Based Colorful makeup Body Painting Palette
aliexpress.com
$450.30
KA KL 5LS 5LK 5LR CVT Transmission Valve Body Suit 27000-5X9-004 27000-5X9-014 For Honda Accord Civic CR-V
aliexpress.com
$3.45
Artificial Violet Branches Simulated Violet Stems Faux Flower Bouquet Fake Lifelike Flower Decor Wedding Living Room Home Office
aliexpress.com
$3.29
Matte Phone Case for Huawei P50 P40 P30 P20 MATE 40 30 20 PRO PLUS Y7P Y8P Case Funda Coque Capa Shell Anime Power Chainsaw Man
aliexpress.com
$1.27
Адаптер для пылесоса, практичный разъем, прочные инструменты для очистки, преобразователь, аксессуары для переноса, детали, серебристо-серый
aliexpress.com
$20.79
Осеннее сексуальное тонкое пуловер с открытой талией, вязаное платье, женское повседневное с круглым вырезом, мини-свитер с длинным рукавом...
aliexpress.com
$200.09
CPLA19H422AC Car Rear View Camera Parking Assist Backup Reversing Camera Night Vision With Guild Line For Aurora
aliexpress.com
$23.91
men summer hooded tshirts new male casual loose short sleeved zipper designs tees for male sports wear tees clothing, White;black
dhgate.com
$16.65
Cute Dolphin 3D Printed Sherpa Blanket Couch Quilt Cover Travel Bedding Outlet Velvet Plush Throw Fleece Blanket Bedspread 03
aliexpress.com
$17.36
Portable INU Body Deep Massage Vacuum Cans Anti-Cellulite Massager Therapy Treatment Cellulite Suction Cup EU&US Plug
aliexpress.com
$65.68
new thick winter jacket coats women long down cotton parkas big fur collar and pocket warm thicken parkas female outwear, Black
dhgate.com
$44.32
for women gifts boy body design painted fashion necklace handmade rectangle shape choker necklace jewelry multi designs, Silver
dhgate.com
$22.73
summer 2020 women's transparent single shoulder mother bag large capacity oblique cross bag tote
dhgate.com
$29.27
casual belts for women imitation leather pu vintage thin women ceinture femme waistband, Black;brown
dhgate.com
$19.71
Motorcycle Front Rear Fender Mudguard Plastic Wheel For Mini Trail Monkey Bike Black for Honda Z50 50R Durable
aliexpress.com
$41.15
For Yamaha YP250 Majesty 250 2000-2007 01 02 03 04 05 06 Magneto Engine Stator Generator Charging Coil
aliexpress.com
$5.46
Fashion Women's Long Sleeve Fleece Loose Leopard Winter Warm Hoodies Casual Jumper Pullover Tops
aliexpress.com
$1.53
Gold Shark baby balloon marine theme park birthday party decoration Gold confetti cartoon balloon kids baby shower supplies
aliexpress.com
$10.64
3pcs/lot hot sale Dr.cap bear plush toy cute high quality stuffed soft Teddy bear doll for children birthday graduation gift
aliexpress.com
$6.34
Senlissi- 18K Gold Plated 8mm Natural Freshwater PINK Bread Pearl and 925 Sterling Silver Stud Earrings for Women Jewelry Gifts
aliexpress.com
$338.60
Настенная доска с отверстиями 6 мм, стол с круглым отверстием, доска с отверстиями для входа в гостиную, многофункциональная красочная доска для рукоделия, ручное хранилище
aliexpress.ru
$53.77
Аккумулятор для ноутбука B31N1842 11.52V 42WH для ASUS VivoBook 15 F513EA K513E KM513UA M513IA S513EA S531F S533UA X513EA X531FA X531FL
aliexpress.ru

![Пенал для карандашей Sanrio Characters Clear 2 Room Sanrio [Pen Pouch]
Пенал для карандашей Sanrio Characters Clear 2 Room Sanrio [Pen Pouch]](http://img.joomcdn.net/60d9421a548146f9f9e379cf64e45e0eebd798aa_original.jpeg)





